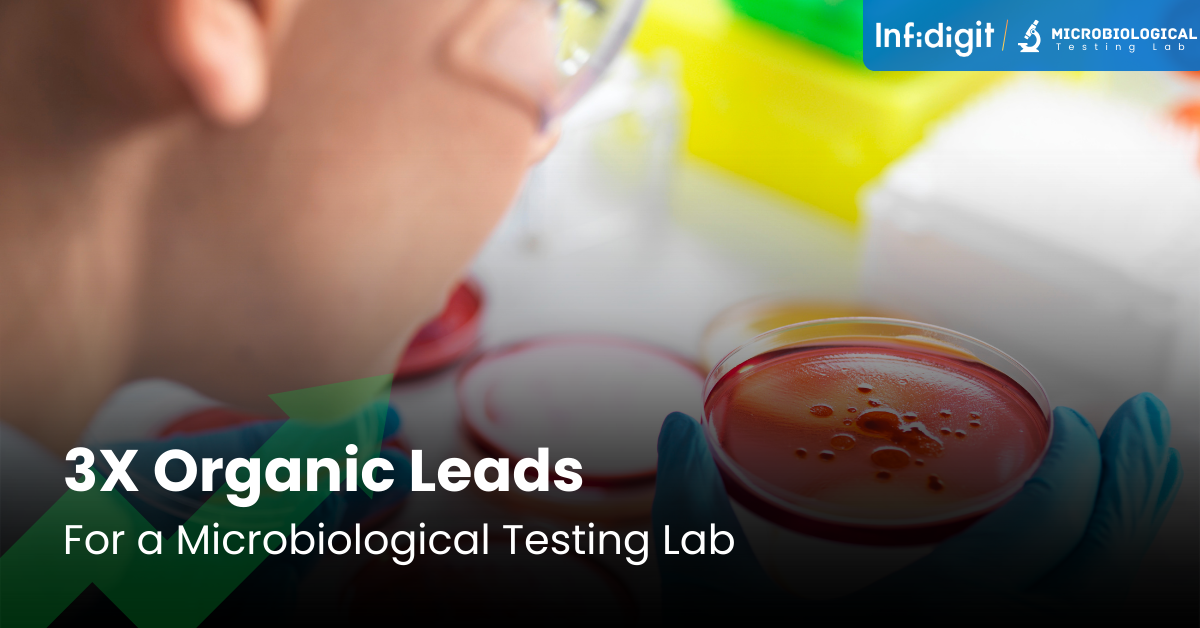

Growth Stories
That Inspire Action
Our clients are at the heart of everything we do. Hear from them directly about how we’ve helped them overcome challenges, grow their businesses, and achieve success.

Infidigit is a CMO’s most preferred partner



3.1B+
Organic Sessions
39M+
Leads Generated
135+
Case Studies
80+
Awards
Home > Case Study